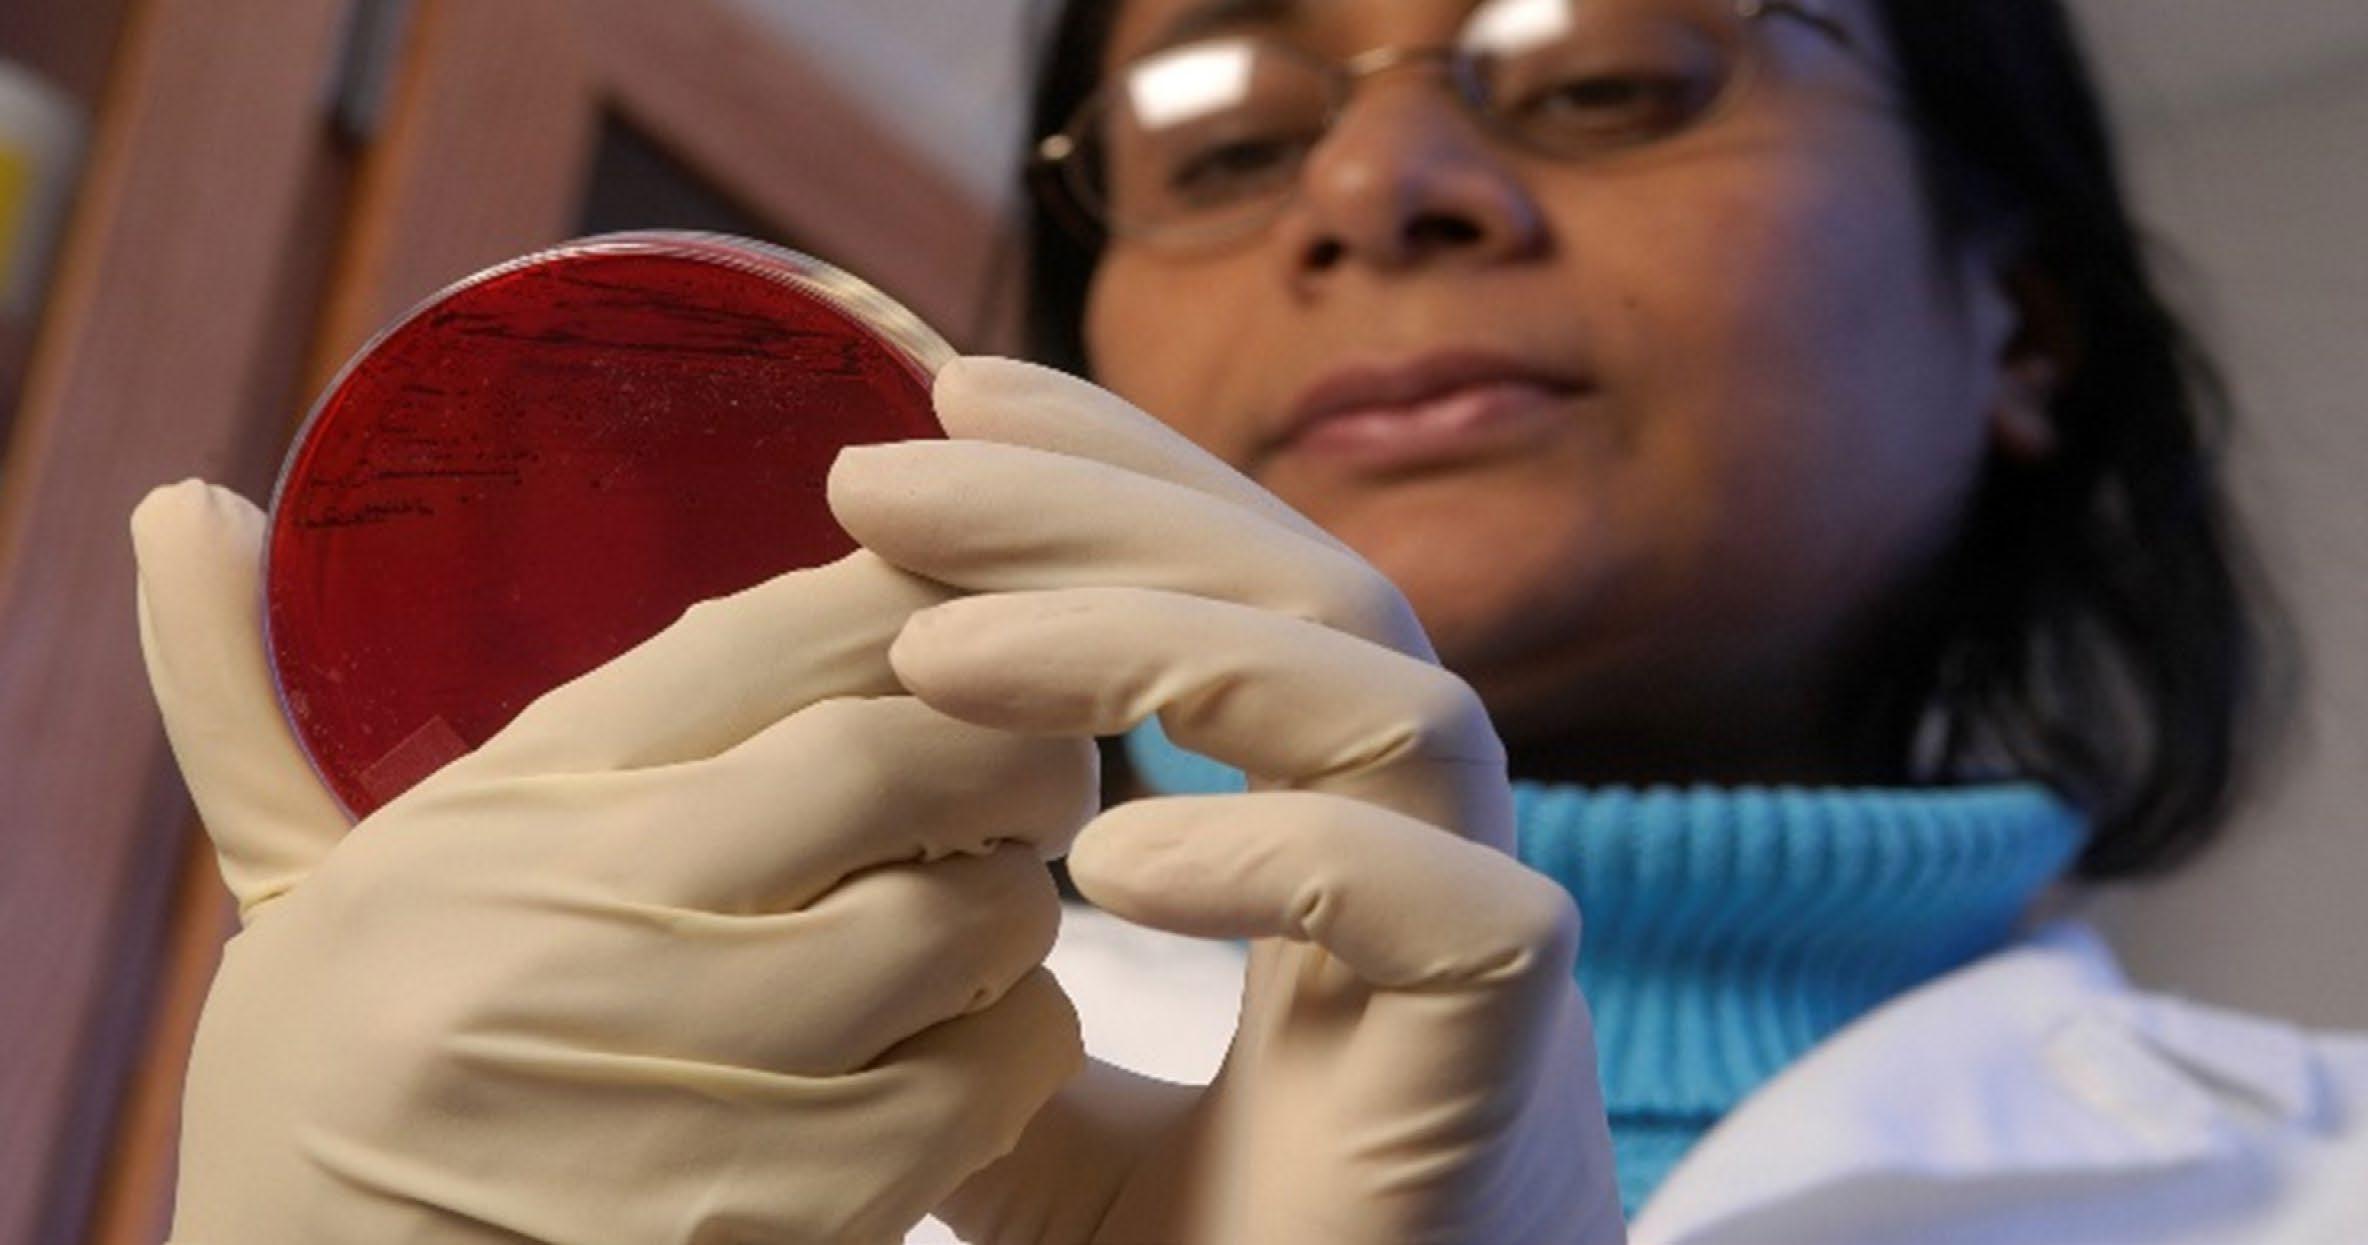

THROUGH EDUCATION, EXTENSION & RESEARCH





The 1890 Land-grant Universities are historically Black universities that were established under the Second Morrill Act of 1890. These 19 universities, located in the southern region of the Unites States, provide innovative, research-based programs that empower, uplift and educate diverse students and underserved communities.
The Association of Extension Administrators, Association of 1890 Research Directors, Council of 1890 Deans of Agriculture and the U.S. Department of Agriculture (USDA)/1890 Task Force are among the official representative bodies of the 1890 Land-grant Universities, supporting Cooperative Extension, research and agricultural education. The USDA’s National Institute of Food and Agriculture and other funding agencies, states and Congress administer funds to the 1890s for the development of programs in these three mission areas.
The featured impacts in this publication, created by the 1890 Land-grant Communications Committee, are just a few examples of the many ways 1890 Land-grant Universities are making a positive difference in the world every year.
To learn more, visit www.1890aea.org or wwwcp.umes.edu/ard.
1890 Land-grant Universities
• Alabama Agricultural and Mechanical University
• Alcorn State University
• Central State University
• Delaware State University
• Florida Agricultural and Mechanical University
• Fort Valley State University
• Kentucky State University
• Langston University
• Lincoln University
• North Carolina Agricultural and Technical State University
• Prairie View Agricultural and Mechanical University
• South Carolina State University
• Southern University and Agricultural and Mechanical College
• Tennessee State University
• Tuskegee University
• University of Arkansas Pine Bluff
• University of Maryland Eastern Shore
• Virginia State University
• West Virginia State University



Alabama Agricultural and Mechanical University (AAMU) is a historic, student-friendly and community-focused institution. As a historically Black university and a traditional 1890 landgrant institution, AAMU functions as a teaching, research and public service institution, which includes the Alabama Cooperative Extension System. Founded in 1875 by Dr. William Hooper Councill, a former slave, AAMU is a progressive institution committed to academic excellence. The campus is situated on “The Hill” just a short distance from downtown Huntsville, where the school was founded.
Academically, AAMU provides more than
60 undergraduate, graduate and certificate programs and concentrations, a diverse international faculty and 50plus student organizations. It also has an extensive alumni network of politicians, educators, entrepreneurs, authors, scientists, artists and other reputable change agents on a local, national and international stage.
The Division of Research and Economic Development at AAMU works with teams of talented researchers and students on a wide range of innovative projects. These projects lead to impactful benefits for the whole world and can be delivered to the public through AAMU’s outreach efforts.
The Alabama Cooperative Extension System (Alabama Extension) is the primary outreach and engagement organization for the land-grant mission of AAMU and Auburn University in cooperation with Tuskegee University. Alabama
Extension takes the university to the people by offering sciencebased solutions that better people, homes, businesses and communities. These efforts are often delivered to the public in collaboration with dedicated partners.
Minority students are underrepresented in agricultural fields such as forestry. The College of Agricultural, Life and Natural Sciences (CALNS) at Alabama A&M University (AAMU) adheres to the traditional land-grant concept (education, research and Extension) by providing students with a dynamic opportunity to prepare for careers in agriculture or related sciences. CALNS
offers multiple degrees that include areas of specialization, minors and concentrations in 10 Bachelor of Science, eight Master of Science and two doctoral programs.
The departments of Family and Consumer Sciences and Food and Animal Sciences, as well as the forestry program, have garnered national recognition. For example, the AAMU Fire Dawgs is the nation’s first
One in 6 Americans is 65 years of age or older. This population is expected to double by 2040. As adults age, the challenges to meet their needs also grow. That’s why the Successful Aging Initiative (SAI) at Alabama
A&M University (Alabama Cooperative Extension System) helps seniors age successfully at home. In 2022, 5,120 participants learned life management strategies, including estate planning, fall prevention, money
wildland fire-fighting crew certified by the United States Forest Service, resulting in a 99% hiring rate. The 1890 Scholarship program has also enhanced enrollment due to increased funding from EvansAllen, McIntire-Stennis and stakeholder donations.
Historically Black colleges and universities, such as AAMU, are needed to advance Black professionals in the nation.
management, identity fraud, caretaking and other topics related to aging.
More than a month after participating in programming efforts, a delayed post-assessment survey among 141 individuals
indicated that behaviors were changing as follows:
• 87% adopted healthy living strategies.
• 74% created a will and assigned a power of attorney.
• 89% checked for signs of identify fraud.
• 83% reduced impulsive spending.
• 84% made environmental changes to prevent falling.
• 80% avoided sharing personal information over the phone.
Adopting these practices helps to increase personal wealth and save millions of dollars in areas such as health care, identity theft and probate court costs among older adults.

The reniform nematode (RN) is a common pest for cotton producers in the United States, including Alabama, Mississippi and Louisiana, resulting in annual losses of $100 million. In addition, it threatens the cotton industry that creates more than
400,000 jobs and annual revenue of $25 billion in products and services. Invisible to the naked eye, RNs live in soil and attack the roots of plants. As many as 30 nematodes or more can live in one tablespoon of soil.
To address this problem, a molecular biology professor and scientist led a team of research students to become the first to sequence and identify the rhizosphere-specific microbial abundance and diversity associated

with the RN. The primary goal of this effort was to understand the microbes that contribute to RNs’ formidable parasitism in 16 counties in north Alabama. Sequencing of the soil microbiome associated with RN has aided in understanding microbial abundance, diversity and their role in determining the parasitic nature of RN. The control strategies developed from this study could help the cotton industry maintain its value, productivity and employment opportunities.
AGRICULTURAL SYSTEMS Reniform nematode female on a cotton seedling root. YOUTHS, FAMILIES & COMMUNITIESWalking is something people do as they go from the car to the office. You do it when you take a stroll around the block with your dog. You even do it when moving from your couch to the fridge for a snack. It is something that we do consistently throughout the day without thinking, and people who walk regularly swear by the health and psychological benefits of their daily walk.
Research shows that walking at a brisk pace for about 30 minutes a day leads to long-term health benefits. Regular walking can lower your risk of high blood pressure, heart disease and diabetes. It can also strengthen

held every year on the first Wednesday of April. In 2023, the Alcorn Extension Program’s Family and Consumer Sciences (FCS) and 4-H educators led an exuberant program, promoting healthier lifestyle choices through daily exercise and nutritional drinks at the Sister Thea Bowman School’s celebration of National Walking Day.
Principal Christopher Payne shared, “It is important that our students learn in-depth
knowledge of how to make smart and healthy choices. Eating healthy and participating in daily exercise is especially important for students who are interested in sports.”
After FCS led a 15-minute brisk walk, participants indulged in a post workout nutritious recovery drink and received nutritional information. The participants shared excitement of their collected learning.
Approximately 19% of Mississippi residents grapple with food insecurity and the challenge of accessing fresh produce such as fruits and vegetables. Gardens offer a valuable solution to enhance food security and advance public health.
While many households in southwest Mississippi are engaged in gardening, gardeners face various hurdles in effectively managing their gardens. These challenges stem from limited knowledge and resources, which can impact the long-
term success of their gardening efforts. By achieving higher yields through the cultivation of superior vegetable varieties, these households collectively could save millions of dollars on their food expenses.
In an effort to promote
successful gardening practices, the Alcorn State University Extension Program, in collaboration with government agencies, universities and nonprofit organizations, organized 18 workshops during the 2022-23 period. These workshops took place across 11 southwest counties in Mississippi, attracting 812 gardeners. Participants received comprehensive instruction on
a wide array of topics related to community and container gardening, including site selection, garden preparation, irrigation, raised bed production, crop rotations and pest management practices.
According to a survey conducted among the participants, more than 98% incorporated new varieties into their gardens, and 91% adjusted their gardening

methods. Also, 98% reported increased garden productivity. An estimate suggests that each farmer employing these effective garden management practices could save more than $5,000. Consequently, the adoption of these knowledge-driven changes in garden management has the potential to generate a cumulative savings of $4,060,000 ($5,000 x 812 = $4,060,000) for the participating farmers.

Scholarship program, which rewards academic excellence, a core CSU value.
These scholarships allay students’ financial concerns so they can focus on their studies. David Scott Scholarship recipients gain outside classroom knowledge by engaging in research led by experts addressing current critical issues, including
enhancing food nutrition and health systems.
Extension professionals use knowledge generated by CSU researchers and students, along with other evidencebased information, to improve individuals, organizations and communities. CSU Extension is increasing food security across Ohio through programming by
The David Scott Scholarships have significantly improved student success at Central State University (CSU) by lowering
the cost of education and producing the next generation of agricultural leaders, particularly from underrepresented groups.
agriculture and natural resources experts teaching people how to farm, community and economic development agents demonstrating proper business practices to citizens, and family and consumer sciences professionals conducting healthy lifestyle workshops.
Scholarships are awarded to students in food and agriculturerelated majors based on their academic performance. The
1890 David Scott scholarships have had tremendous impact on student success at CSU. Of the 68 awardees from academic years 2020-21 through 202223, 21 students graduated and 32 students are still enrolled at CSU for a success rate of 78%. The scholarships also resulted
in an increase in enrollment at CSU. There are 101 scholarship recipients for the 2023-24 academic year, and 47 are new recipients.
Investing in student success increases the socioeconomic condition of individual students
and their communities. Bachelor degree holders will earn more than twice the income of high school graduates over their lifetime. Higher educational attainment also reduces the disparities in wealth, income and health.
Food deserts exist in communities where access to affordable, healthy foods is limited, which creates greater risk for obesity, heart disease and diabetes.
One solution for increasing access to healthy foods is to create farms to provide fresh produce locally for the community. For that reason, Central State University (CSU) Extension’s Growing Communities program built an infrastructure of new farmers in underserved and underrepresented communities by creating urban incubator farms. CSU Extension educators in Agriculture and Natural Resources and Community and Economic Development, along with local farm mentors, provide the training.
As a result, urban farms increased in the Edgemont and Trotwood communities. The farmers who received their certificate of completion from the classes identified their intent to start a farming operation. Additionally, farmers from each incubator farm site formed a cooperative for their farming enterprise to continue collaboration as a cohort.
The cooperatives are providing farmers with the opportunity to farm together, increase their access to available land and increase resources for marketing in various venues. The Edgemont incubator farm has established a regular farm market. The Trotwood incubator farm is marketing at several local outlets. Also, regular classes on managing diabetes were held in the
communities to help people gain a better understanding of diabetes self-care.
In the second year, some of the farm managers moved into the farm mentor role and gained growth as a farmer and in leading people. Funding for the program is from the U.S. Department of Agriculture’s National Institute of Food and Agriculture 1890 Extension Capacity Grant and the 1890 Capacity Building Grant.

Non-point source nutrient runoff in agricultural watersheds, particularly nitrogen and phosphorus, continues to threaten the quality of surface and groundwater in Ohio watersheds. Impaired water quality detrimentally affects drinking water quality, recreational water uses and aquatic life. Increased rainfall intensity and frequency due to climate change could further exasperate this problem and may end up impacting vulnerable communities to a greater degree.

Improving soil health and consequently water quality through implementation of agricultural best management practices (BMPs) is critical for achieving the twin goal of sustainable agricultural production and effective environmental stewardship. These goals could only be realized through the application of evidence-based scientific solutions and strong stakeholder partnerships.
Therefore, Central State University connected with several regional partners to identify targeted locations for implementation of BMPs in southwestern Ohio watersheds. The practices include controlled drainage, riparian buffers, bioreactors, grassed waterways, cascading waterways, and water and sediment control basins. The implementation of BMPs in the watersheds is being achieved through targeted outreach to producers and landowners in the communities and through the development of NonPoint Source Implementation Strategies (NPSIS) plans for watersheds at hydrologic unit code (HUC) 12 scales. The focus is on the 20-county watershed region of southwestern Ohio that drains into the Ohio River via the Great and Little Miami Rivers.
Delaware State University (DSU) is committed to agricultural and forestry Extension activities aligned with the U.S. Department of Agriculture’s strategic plan. These critical areas include:
1. Combat Climate Change to Support America’s Working Lands, Natural Resources and Communities. DSU will continue to investigate key climate adaptation practices at farm and forest sites within the region and demonstrate a variety of practices to help local producers adapt to a changing climate.
2. Equitable, Resilient and Prosperous Agricultural System. Applied research in Extension will shape the
research and technology agenda while contributing to the pillars of agriculture-led economic growth, resilience, nutrition and water security.
3. Foster an Equitable and Competitive Marketplace for All Agricultural Producers.
4. Safe, Nutritious Food. FY24 brings a focus on promoting hands-on nutrition education and awareness surrounding food safety and health. New initiatives in DSU’s urban agriculture vertical farming encourage eligible seniors and underserved communities to eat more locally grown vegetables.
5. Attract, Inspire and Retain an Engaged and Motivated Workforce. DSU Extension
engages diverse communities and disseminates broad impacts through research, education, Extension and integrated activities to address current and future challenges.
DSU Cooperative Extension is equipping the next generation workforce with knowledge and expertise to support the Cooperative Extension System. Its hallmark initiatives include the creation of career pathways for veterans in agriculture. Another initiative is the application of technology, such as artificial intelligence, machine learning, remote sensing and Internet of Things, for farming and farm management, natural resources conservation and food deserts.
In Delaware, the poverty rate for individuals was 12% in 2015. According to the 201418 American Community Survey, the poverty rates in New Castle, Kent and Sussex counties were 11.4%, 13.6% and 11.7% respectively. Research has indicated that poverty is associated with poor nutrition and an increased risk of many diseases.
Delaware Cooperative Extension serves individuals from diverse backgrounds and needs conducting researchbased educational programs promoting healthy lifestyles, family economic stability, youth development and leadership. The aim is to strengthen the capacity of families to nurture, support and guide their members throughout their lives.
“...the state of Delaware has made marked improvements in reducing the burden of chronic diseases through the development of task forces and the Delaware State Health Improvement Plan.”
The Milbank Memorial Fund Report of 2017 states that from 2007-12, the state of Delaware has made marked improvements in reducing the burden of chronic diseases through the development of task forces and the Delaware State Health Improvement Plan. Delaware Cooperative Extension is also an active partner with the Robert Wood Johnston Foundation. These initiatives around health and policy, systems and environment change support Cooperative Extension in its community work around nutrition and wellness. In addition, the Supplemental Nutrition Assistance Program – Education conducts a six-week program in elementary schools using the Choose Health: Food, Fun and Fitness curriculum. Students learn to read the nutrition facts label on foods by discussing food contents and learning to calculate fat and sugar into teaspoons.
Florida’s natural resources and environment are vital to a strong economy and sustainable communities. The natural environment is directly connected to tourism, sustainable community development, human health and jobs. However, people of color and socioeconomically challenged communities are disproportionately impacted by climate change and environmental degradation. Therefore, since 1998, the Forestry and Conservation Education (FACE) Program at Florida Agricultural and Mechanical University has provided opportunities for youths and adults to explore forestry, natural resources,
environment, agriculture and other related careers. The program has expanded to year-round natural resources conservation and environmental stewardship education, delivering inclusive programming that promotes environmental awareness, understanding and literacy. It engages students in handson, experience-based learning in forestry, natural resources and environmental education through classroom enrichment, field days, after-school programs and summer camps. It also offers professional development opportunities for in-service and pre-service teachers.
In 2022, 13 students in grades 7-9 participated in the summer
program, where they gained hands-on learning about forestry, plant science, soils, watersheds, water quality and wildlife. Also, 246 students in grades 2-5 participated in enrichment environmental activities in local schools, and 52 pre-service teachers completed the Project Learning Tree training.
As a result, the pre-service teachers are using literature as a foundational tool for teaching environmental science in area Title I schools, impacting more than 500 students. One teacher served as an environmental education intern for the program and learned how to incorporate environmental education into their curricula.
Fort Valley State University (FVSU) is home to the Wildcats and Georgia’s only 1890 Land-grant University. With more than 2,500 students, the historically Black university is the top producer of African American students who earn bachelor’s degrees in agriculture, agriculture operations and related sciences. FVSU also offers the only certified veterinary technology program in the state. The College of Agriculture, Family Sciences and Technology provides solid career foundations in agricultural sciences, engineering technology, family and consumer sciences, and veterinary science and public health. In addition to academics, impactful research and outreach allows professionals to meet small farmers and underserved communities where they are and
provide them with the resources they need to thrive.
Through the Agricultural Research Station and Georgia
Small Ruminant Research and Extension Center, scientists engage in areas of agricultural economics, bioenergy and climate change, food safety, small ruminants and specialty plant biotechnology. These studies generate new knowledge and technology to enhance the agricultural industry and Georgia residents’ quality
such as sheep and goats.
Furthermore, the Cooperative Extension Program provides educational services through its staff of program leaders, specialists, county agents, county program assistants and support personnel. These experts offer practical, solutionoriented learning opportunities in agricultural and natural resources, family and consumer sciences, community resource development and 4-H youth

The College of Agriculture, Family Sciences and Technology (CAFST) at Fort Valley State University (FVSU) can provide students with a gateway to Georgia’s multibillion-dollar agricultural industry. Students engage in cutting-edge research led by world-renowned scientists, participate in internships, earn scholarships and awards, and study abroad.
Since 2020, more than 158 CAFST undergraduates have benefited from the FVSU 1890 Scholarship and the U.S. Department of Agriculture (USDA) 1890 National Scholars Program. In addition, students intern at partner universities like Utah State University, the University of Georgia and the University of California, Davis to further their research engagement.
Anijha Baker, a plant sciencebiotechnology major, interned at the University of Maryland Eastern Shore in 2022. An FVSU 1890 scholar, Baker’s

research focused on marine biology, where she experimented with Sambucus nigra extracts. She is interested in serving in the military and becoming a botanist.
Furthermore, seven FVSU agricultural students embarked on an 11-day journey to Ghana and Côte d’Ivoire in 2022 to learn about the operation of cocoa and shea butter production. The Center of Excellence for Global Food Security and Defense, funded by the USDA’s National Institute of
Food and Agriculture, supported this international learning experience.
“This experience and the knowledge I’ve gained have been so pivotal for me in wanting to become a change agent within the agricultural sector. I wish many more could experience this,” expressed Casey Hunter, an animal science major.
More than 50% of FVSU students, who desire to do so, obtain employment or attend graduate or professional school within six months of graduation.
Rural communities in Georgia often lack adequate technology resources, including broadband access and personal computers for home use. Many students often do their work at public access locations, facing barriers such as limited hours, lack of transportation and limited digital skills.
For that reason, Fort Valley State University (FVSU) is reducing these barriers using loaner laptops and hotspots, digital skills training and outfitting community hub sites to increase access for underserved and unserved students residing in anchor communities.
FVSU’s Cooperative Extension partnered with AT&T and the Fort Valley Youth Center of Excellence to distribute 100 computers to Peach County K-12 students, provided broadband access to 80 FVSU students through hotspots and ordered more than 750 laptops for distribution to residents in Macon, Peach, Crawford and Taylor counties.
Tracy Preston and her 13-yearold daughter, Aydriana Jackson, were ecstatic to receive a computer at no cost from AT&T.
“It’s a Godsend, especially for low-income parents like myself,” said Preston, a Peach County

“This is an excellent opportunity for us to enhance our outreach efforts, but more importantly, this is a chance to reach many kids in the community with technology”
native. “Our previous computer was damaged, and I was wondering how I was going to replace it, but this came in right on time.”
“This is an excellent opportunity for us to enhance our outreach efforts, but more importantly, this is a chance to reach many kids in the community with technology,” said Dr. Mark Latimore Jr., FVSU’s associate dean for Cooperative Extension.
“As broadband continues to increase in rural areas, our students really need to be on board as far as the proper equipment is concerned.”
YOUTHS, FAMILIES & COMMUNITIES
The sweet potato whitefly is the worst nightmare for vegetable crops worldwide, including vegetable growers in middle Georgia. This pest damages plants with direct feeding and indirect harm by secreting honeydew, causing plant disorders and transmitting plant viruses. These direct and indirect damages result in significant economic losses to farmers.
Vegetable growers currently rely on applying chemical insecticides against the whitefly, which has developed resistance to several insecticides. Therefore, there is a need for alternative integrated pest management (IPM) strategies. Host plant
resistance and biopathogens present potential IPM measures against the whitefly.
For that reason, Fort Valley State University (FVSU) researchers have identified cultivars of snap beans and squash that are less susceptible to the whitefly. Researchers evaluated cultivar susceptibilities and efficacy of entomopathogens. This study emphasizes the influence of climatic factors on whitefly infestations.
Results reveal that the most resistant snap bean cultivars against the whitefly in Georgia are Royal burgundy, Jade, Golden Rod and Long Tendergreen. The most resistant squash cultivars against the

whitefly are the Golden goose hybrid, black beauty and Golden glory. Also, biological control studies identified Heterorhabditis floridesis (K22 strain) as the most virulent strain of entomopathogenic nematode against the whitefly on tomatoes. Additional study is focusing on identifying application methods that can enhance the virulence of select strains of entomopathogens against the whitefly.
This research demonstrates the potential integration of cultivar screening for resistance to the whitefly with the application of biopathogens, such as entomopathogens, to protect vegetable crops from a whitefly infestation.
ENVIRONMENTAL STEWARDSHIP
Kentucky State University’s (KSU) Land-grant Program and Cooperative Extension Service strengthen underserved communities, families, farmers, individuals and youths to improve their quality of life with state-of-the-art, research-based educational programs.
KSU recently celebrated the 25th anniversary of its Third Thursday Thing sustainable agriculture workshop and hosted the 25th Small, LimitedResource, Minority Farmers Conference. These and other programs connect small farmers in Kentucky with vital resources, information and personnel.
In addition, the Small-Scale Farm Grant Program puts money into the hands of small farmers and has a life-changing impact. KSU’s aquaculture and pawpaw programs are world-renowned and continue to host regional, national and international visitors to its Harold R. Benson Research and Demonstration Farm, Aquaculture Research Center, Environmental Education and Research Center, and Rosenwald Center for 4-H Youth Development. KSU is always striving to find innovative ways to continue serving stakeholders across the Commonwealth of Kentucky.
Through AgDiscovery, high school students have the opportunity to get hands-on experience in animal science and veterinary medicine. And, in some cases, they may have a bird land on their head at the Louisville Zoo.
The two-week residential camp is packed with lab and research projects, workshops and site visits. The U.S. Department of Agriculture’s (USDA) Animal and Plant Health Inspection Service (APHIS) partners with universities, including Kentucky State, to host AgDiscovery. High school students in grades 9-12 are eligible to apply and participate.
“AgDiscovery is important because it allows its participants to learn about the agricultural industry and get hands-
on experience while in the program,” said Danielle Kinder, 4-H Youth Development Extension area agent at Kentucky State University.
Kinder attended AgDiscovery when she was a sophomore in high school, which was “a huge eye opener.” She had plans to be a veterinarian, but AgDiscovery helped her realize a variety of careers that she could pursue that did not require veterinary training but would still allow her to work with animals. Kinder also formed relationships with Dr. John Hollis of USDAAPHIS and with Dr. Travella Free, former program coordinator at Kentucky State.
“If it wasn’t for these
relationships and the employment opportunities through the AgDiscovery Program, I would not be where I am today,” Kinder said. She enjoyed AgDiscovery so much that she returned as a counselor from 2016-18 and in 2022. In 2019, she served as the program/research assistant.

By offering water quality testing, Kentucky State University (KSU) is helping small farmers ensure their products are safe.
The grant titled, “Helping Small-
scale and Socially Disadvantaged Growers in Improving Water Quality to Ensure Food Safety of Produce for Consumers and Increased Sales,” received nearly
$350,000 in funding from the U.S. Department of Agriculture in 2021.
This project, led by KSU, originated from a 2014-17 Evans-
Allen project that focused on microbial quality of fruits and vegetables. Research revealed that about 17% to 20% of water samples were “substantially contaminated and stayed contaminated for a big chunk of time.”
Small farmers in Kentucky wanted to hold their water to a high standard, but they needed help. KSU has now established or is in the process of establishing water quality testing labs across the state on its campus in Frankfort and in Whitesburg, Hodgenville and Bowling Green.
At no cost to them, farmers can visit one of these labs to gather a water sample from their farm, then return the sample to the lab to be tested.
Timothy Lane Breeding of Rocket Farm in Jeremiah, Kentucky, has already utilized the water quality testing lab in Whitesburg. Rocket Farm typically grows potatoes, beans, corn, Brussel sprouts, peppers and other produce. Due to the flooding, some of the water has higher contamination, so not all the produce can be grown this year. However, Breeding said the

farm is set for flowers and herbs.
Breeding said having the water quality testing lab is “Very, very, very beneficial, not just for our farm, but for all the farmers in the community.”

If more people in Kentucky eat tilapia, that means more Kentucky small farmers can profitably raise tilapia.
Kentucky State University (KSU) researchers received a U.S. Department of Agriculturefunded grant titled, “Expanding Aquaculture and Healthy Food Choices to Reduce Economic and Health Disparities Affecting Minority and Limited-Resource Stakeholders.” This grant, funded for $250,000 from 2021 to 2024,
If more people in Kentucky eat tilapia, that means more Kentucky small farmers can profitably raise tilapia.
is focused on strengthening farmers, businesses and other stakeholders and impacting healthier living.
This project includes
collaboration with multiple areas, including Extension and the School of Agriculture, Food and the Environment. Tilapia is a popular fish to eat across the world but less so in the United States. KSU researchers note that some people label tilapia as a man-made fish and refuse to eat it, but tilapia is natural and comes from the Earth. Therefore, the grant team is working on a series of videos that cover fish processing, making healthy recipes with tilapia and more to educate people about handling and cooking the fish.
Aquaculture graduate student
Uchechukwu Ohajiudu did a cooking demonstration of pepper soup, a favorite recipe from his native Nigeria. He grew up in the kitchen with his mom as she made the soup. She learned not to leave him unattended or else he would steal a taste. The dish can be made with any meat, including tilapia. The signature ingredient is pepper.
“I get lonely, then I’ll just get a few ingredients and then make it. Having pepper soup just takes my mind back home,” Ohajuidu said.
Faculty and students at Langston University’s Sherman Lewis School of Agriculture and Applied Sciences completed a successful week-long study abroad trip in 2022 to Kingston and Port Antonio, Jamaica.
The objective of the Travel Abroad Student-Study Program was to broaden students’ insights into international agriculture communities and provide cultural exposure. The team visited and toured four parishes (St. Catherine, St. Clarendon, Portland and St. Mary) in Jamaica. Partial funding for the program was provided through a grant supported by the Center of Excellence.
Insightful tours included the College of Agricultural Science and Education (CASE) and three local Green Bottom Farms to observe each location’s analysis of production costs on feed and
nutrition to produce healthy crops and livestock.
Langston University’s Sherman Lewis School of Agriculture and Applied Science is committed to supporting experiential learning opportunities for students by ensuring that international travel/study abroad programs remain core opportunities for LU-SL/ SAAS students.
The objectives of broadening insights into international agriculture and cultural exposure were achieved through the combined efforts of Langston University, the Rural Agricultural Development Authority and CASE representatives.
“This study-abroad trip was impactful because it made me appreciate agriculture. I fell in love with the people and the culture. This program will grow

and flourish other students’ dreams. It made me realize that I want to travel around the world to help farms produce the best commodity,” said student Kayla Smith, who has a crop and science concentration.

Participants learned how to market and profit from small farm enterprises and how to support local community food systems. They also learned about plant system sustainability and smallscale animal production. The event included presentations, demonstrations, displays and exhibits, and youth Ag-STEM activities.
The Langston University Sherman Lewis School of Agriculture and Applied Sciences held its pioneering Food, Agriculture and Natural Resources Conference in 2023 on the Langston University campus in Oklahoma. This joint symposium focused on sustainable small farmers, including goat and sheep enterprises, from production through consumption. The two-day event provided an enriching venue for small and beginning farmers, ranchers and small operations.
In 2023, the Goat Field Day, established in 1986, and the Small Farmers’ Conference, established in 1999, combined into the Conference on Goats, Hair Sheep and Sustainable
Small Farming, which doubled their impact.
Both conferences generally attract more than 200 participants each. With the expansion of new Cooperative Extension programs at Langston University, the merger of the two conferences into a super conference was the most logical choice to satisfy the needs and requests of all stakeholders. The conference places an intentional emphasis on youth activities, which culminated in a Monarch Butterfly release for the 2023 conference.
“We really gained some valuable information from the goat and sheep field workday. Thank you so much for all of the hard work that you and everyone else put in to make it a success,” said one participant.
Recently overhauled by Langston University’s Sherman Lewis School of Agriculture and Applied Sciences, the Langston Interactive Nutrient Calculation (LINC) system for goats provides an excellent example of a “bridge” linking research, Extension and education.
LINC applies the energy and protein requirements of goats and includes equations to predict feed intake. For nutrient requirement recommendations to be of greatest utility, a simple means of application is crucial, which is the purpose of LINC. Therefore, scientists upgraded
the system to LINC 2.0 (http://40.65.112.141/). Software coding was completely revamped to be compatible with current devices and clientele expectations, along with development of software that does not require internet access.
Langston researchers provided several training sessions on LINC 2.0 for undergraduate students, visiting scientists, individual farmers, farmer associations and international projects in Jamaica, Algeria, Poland and China. Also, there has been training provided for the American Cashmere Association and at events such as the annual Small Ruminant and

Small Farmer Conferences of Langston University.
The most important factor affecting profitability of the goat enterprise is feed cost. LINC enables producers to accurately predict the nutritional requirements of different breeds and classes of goats, linking it with production level and type. Estimating the most costeffective diets or supplement types allows for sustainable and profitable goat production while at the same time lessening the effect on climate change. Because the project focuses on enhancing a technology transfer vehicle, it is increasing the impact potential of the Langston University Extension program.
In alignment with the U.S. Department of Agriculture’s top research priority areas, Lincoln University’s (LU) Cooperative Research Program conducts impactful research primarily focused on animal science, plant science, food safety, natural resources and social-economics with an integration of innovative research, education and Extension activities. The program aims to address the critical issues facing agricultural industry and rural communities in state and develop sustainable solutions to the problems, especially for underrepresented, underserved farmers and communities.
LU capacity research efforts are primarily focused on the critical issues identified:
• Sustainable and Resilient Agriculture Systems: Emphasis on sheep/goat breeding, productive physiology, grazing management, poultry operation and freshwater prawn technique, quinoa cultivation, soybean genomics, hydroponic operation,
integrated pest management, organic farming, industrial hemp, policy, value-added products and marketing.
• Environmental and Natural Resource: Climate change, soil health, cover crops, water safety, watershed management, agroforestry management, ecosystem health, ecological risk of contaminants and water quality.
• Health and Health Future: Detection of food contamination, food safety and water biosafety.
In addition to the capacity research, the program also
actively pursues external grant funding to support existing agriculture and food research, student education and training, and leverage research resources through multi-institutional and multi-disciplinary collaborations. The faculties are making efforts to disseminate research findings to stakeholders through peer-reviewed publications and conference or workshop presentations.

The Department of Agriculture and Environmental Sciences Academic program hosted Agriculture Literacy events for students majoring in agriculture. The events were experiential learning opportunities focused on Lincoln University (LU) resources and the academic program minor and emphasis areas.
Each Agriculture Literacy event, except the St. Louis trip, was held on a Tuesday evening for two hours. The average attendance at each lab was 20 students.
These events included:
• Worked in the LU Community Garden and toured the Dickinson Research Center.
• Harvested wild plums and other Missouri native edibles from the LU FINCA EcoFarm.
• Toured the LU Aquaculture Research Facility.
• Met with Missouri Department of Conservation agents at state headquarters and fished in their ponds.
• Traveled to St. Louis (two hours away) for a tour of the Missouri Botanical Gardens.
“students learned how to manage natural resources on a military installation and interacted with veterans and participating agency personnel.”
• Made wild plum jelly in the LU Commercial Kitchen. Students learned about produce safety and food preservation.
• Prepared foods for the annual Student Crawfish Boil at the LU George W. Carver Farm. Students dressed the crawfish and learned to cook them.
Additionally, the wildlife professor and three students recently traveled to Neosho,
Missouri. They provided volunteer assistance over three days to seven disabled veterans, the Missouri Army National Guard and the Missouri Department of Conservation during a managed deer hunt. The students learned how to manage natural resources on a military installation and interacted with veterans and participating agency personnel. The students were also responsible for tagging, field processing and loading the 13 deer that were harvested into a freezer.
The Innovative Small Farmers’ Outreach Program (ISFOP) is set up to assist small farmers and ranchers, especially limited resource, underserved and minority farmers, one of Lincoln University Cooperative Extension’s (LUCE) priority missions.
LUCE launched the ISFOP initiative to provide information, education and training with the ultimate objective of increasing farm income and improving quality of life. ISFOP provided programming to almost 400 small
farm families in 35 counties in Missouri.
During FY 2023, ISFOP staff made 1,144 farm visits (in person or via phone) and conducted 26 workshops as the primary organizer and 20 more as an important collaborator, attended by 891 participants. In addition, several ISFOP staff taught classes and presented at field events attended by 11,365 participants. The cumulative direct contacts from all ISFOP activities were 14,662, and the estimated indirect contacts were more than 49,294.

American families on average increased their income by $1,000, 36 Asian/Hmong families each increased their average income by more than $3,500, and 20 military veterans increased their average income by $385. Also, a farmer received a Natural Resources Conservation Service Environmental Quality Incentives Program grant totaling $8,000. Three ISFOP field staff, joining hands with some of the collaborating farmers, received $158,874 in grant funding from the North Central Sustainable Agriculture Research and Education program during this reporting period.
Almost 70 percent of the farmers adopted at least one of the Good Agricultural Practices, Sustainable Agriculture or Food Safety methodologies, while some adopted as many as four production practices.
Rice is one of the major foods in the world and one of the most important crops in the United States. The average American consumes about 25 pounds of rice per year, and the U.S. is ranked the third largest riceexporting country in the world. A recent survey indicated that rice produced in the southcentral U.S. contained elevated arsenic concentrations due to the historical application of arseniccontaining pesticides.
In an effort to improve the quality and safety of U.S.produced rice and safeguard human health and rice consumers from arseniccontaminated soils, there is an urgent need to develop mitigation strategies. Therefore, a research team of scientists from Lincoln University and governmental agencies conducted experiments through laboratory, greenhouse and field studies. Results indicated that arsenic content in rice grains and rice yields were cultivardependent and influenced by soil-arsenic levels and water management practices. Arsenicresistant cultivars yielded more and contained less arsenic than the susceptible ones. The arsenic accumulation in rice could be significantly reduced by wetdry water management and soil amendments in rice fields.

American rice growers with best management practices to produce high-quality, safer and marketable rice grains, which could protect American rice consumers from the potential health risk of arsenic-elevated rice products and promote a rice-based regional economy.
This research will provide

North Carolina A&T State University’s College of Agriculture and Environmental Sciences provides several program options. These program options accommodate specialization in several areas of the food, agricultural, family and environmental sciences.
The college encourages involvement in cocurricular activities as a means of developing

communication and leadership skills. The Bachelor of Science degree is offered in agricultural education with concentrations in secondary education and agricultural professional service; agricultural and environmental system with concentrations in agribusiness and food industry management, environmental studies, and sustainable land and food systems; food and nutritional sciences with concentrations in food science and human nutrition; child development and family studies with concentrations in child development, early education and family studies - B-K licensure, and child development and family relations; and family and consumer sciences with concentrations in fashion design and merchandising and consumer sciences; and biological engineering, landscape architecture, animal science and laboratory animal science.
The Master of Science degree is offered in agricultural and environmental systems with concentrations in agribusiness and food industry management, integrated animal health systems, and natural and environmental systems; agricultural education with concentrations in professional licensure and professional service; and food and nutritional science.
The Master of Art in Teaching is offered in family and consumer sciences and child development in early education and family studies birth-kindergarten.
The Doctor of Philosophy is offered in agricultural and environmental sciences with concentrations in food science, human nutrition and health, sustainable agriculture and environmental sciences, agribusiness and applied economics, agricultural and Extension education, and sustainable animal production and health.
Currently, the food, agricultural and environmental science disciplines and industries struggle to fill positions with qualified professionals, particularly representative of the global society. Therefore, it is critical to attract highcaliber individuals to food, agricultural and environmental science degree programs that are prepared to enter the workforce with the skills needed to navigate complex issues and problems.
To address this problem, the College of Agriculture and Environmental Sciences (CAES) at North Carolina A&T State University established its annual Winter Agricultural Literacy Fest and Academic Fair. The event brings together secondary agricultural education students from across the state of North Carolina to expose them to the academic and career opportunities available in the food, agricultural and environmental sciences. Representatives from a variety of governmental and private food, agricultural and agribusiness entities deliver presentations at the event. The fair also includes career awareness, leadership and student panels covering topics concerning the food, agricultural and environmental science disciplines and is targeted to middle and secondary students enrolled in agricultural science programs.
As a result of this event, numerous secondary students have matriculated to North Carolina’s various agricultural higher education programs in pursuit of baccalaureate degrees in a plethora of food,
agricultural and environmental science disciplines. This has increased enrollment in the respective programs and promoted student success and agricultural literacy. In addition, there is greater student diversity in the programs that is more reflective of the larger population.
The program improves diversity, equity and inclusion for the future workforce in food, agricultural and environmental sciences, given the importance of these disciplines to mankind’s survival.
 YOUTHS, FAMILIES & COMMUNITIES
YOUTHS, FAMILIES & COMMUNITIES
Digital literacy is increasingly important in society as communication and access to information is delivered through digital technology. Yet, at least one-third of the people in the United States lack basic digital literacy skills to function in society today. It is also estimated that 20 million people or 8.3 million households in the U.S. lacks highspeed broadband internet access. The lack of digital literacy skills and internet access greatly contributes to what is called the digital divide. Programs like 4-H Tech Changemakers (TCM) is

4-H Tech Changemakers was launched by the National 4-H Council to help underserved areas bridge the digital divide using the talents of youths in their communities.
helping to bridge that gap.
4-H Tech Changemakers was launched by the National 4-H Council to help underserved areas bridge the digital divide using the talents of youths in their communities. 4-Hers are trained to teach technology skills such as internet security, social media and Microsoft Office. People who attend these sessions gain employment skills, have more success at their current jobs and learn to use digital technologies to improve their lives.
To date, 20 land-grant universities, including 11 historically Black colleges and universities, participate in Tech Changemakers. In its first year, Extension at North Carolina A&T worked with 21 youths from seven North Carolina
counties to help them become certified 4-H Tech Changemakers.
The youths worked with 1,512 adults in Forsyth, Gates, Hertford, Mecklenburg, Scotland, Vance and Wilson counties. Many of the adults reached were African American with limited technical skills in using broadband and related technologies. Some were also teachers who wanted to learn to use technologies like online games to engage their students.
4-H Tech Changemakers can help build bridges across the digital divide. While 4-Hers gain important leadership skills, the program gives a voice to communities that too often are silenced because they lack connectivity.
Consumption of deep-fat fried foods has been associated with coronary heart diseases, obesity, Type 2 diabetes and cancers. Fried fish and chicken products make up a substantial percentage of the items sold at fast-food restaurants. The quality and type of the oil used for frying is one of the major factors influencing fat uptake in deep-fried foods.
For that reason, North Carolina A&T researchers are developing a novel frying medium using an oleogel to reduce the fat uptake in fried chicken and fish without any compromise in the quality and shelf life of the product.
In this study, researchers used thyme essential oil with an edible sweet potato starch coating to improve the oxidative stability of fried chicken and fish. In another experiment, the researchers
used a commercial dietary fiber with the batter mix of chicken and fish samples for deep frying to see the result in fat uptake, oxidative stability, taste and shelf life of the fried meat.
Frying chicken with oleogels significantly reduced the fat uptake compared to canola oil. The use of thyme essential oil with edible coating also improved the oxidative stability of the fried meat compared to that fried in canola oil. In addition, adding fried dietary fiber significantly reduced the fat uptake, while improving moisture content without any compromise in

color, texture and sensory qualities of the fried chicken and fish.
The fast-food industry can use the frying medium to replace existing commercial frying oils and reduce fat uptake with no compromise in taste, texture and shelf life of food products.
College of Agriculture, Food and Natural Resources at PVAMU
Prairie View A&M University (PVAMU) is empowering underserved student populations and limited resource clientele with a dedication to foster academic excellence, increase health and well-being and enhance economic opportunities through research, education and service in agriculture, food and natural resources in the state of Texas.
There is a need to recruit, retain, educate and graduate professionals to serve the growing needs of the citizens of Texas, the nation and the global community. Therefore, the College of Agriculture, Food and Natural Resources (CAFNR) at PVAMU works closely with the university’s Office of Enrollment Management to target and actively recruit prospective students from area, state and out-of-state high schools.
“...more than 22 students from the agriculture program have been accepted into top-notch schools of veterinary medicine, including Purdue University, Tuskegee University and Texas A&M University.”
Additionally, the college sponsors and hosts experiential summer programs for high school students to attract them into academic programs. Students are encouraged to engage in High Impact Educational Practices (HIEP), such as research, internships, service learning and study abroad, to enhance their success.
The first-year retention rate and
four- and six-year graduation rates have all increased in the past five years. The number of degrees awarded has also increased. CAFNR leads all colleges at PVAMU in the number of students who study abroad. In the past two years, more than 22 students from the agriculture program have been accepted into top-notch schools of veterinary medicine, including Purdue University, Tuskegee University and Texas A&M University. The number of students participating in internships and entering graduate schools has also increased. Students presented and published their research results at major international scientific conferences in the U.S. and in peer-reviewed journals.
Prairie View A&M Cooperative Extension’s Heroes 4-Health program addresses the obesity crisis throughout the state of Texas by empowering youths to teach their peers and community healthy living practices. The youth leaders, also known as Teen Health Ambassadors, are typically in grades 7-12. Youth participants are typically in grades 3-12 living in limited resource African American, Hispanic or Tribal communities.
Heroes 4-Health has been implemented in up to 12 Texas counties. This signature program mobilizes youth participants to address nutritional deficiencies, healthy food choices and physical activity. An additional benefit of participation includes the opportunity to travel to national conferences and share knowledge with youths from across the country.
“This is my first year being a

teen ambassador for Heroes 4-Health,” said Jayden Ingalls. “I really enjoyed how hands-on this program was. I liked it so much that I invited one of my friends to do it with me. We studied the lessons together and taught the kids together.”
Heroes 4-Health has reached 35,675 youths and has trained 715 Teen Health Ambassadors across Texas since 2013. In 2022, 21 new partnerships with grassroots and corporate entities were formed that increased program engagement within participating communities. There have been more than 20,000 common measure surveys collected indicating that more than 90% of participants
have adopted behaviors that lead to healthy lifestyles (drinking more water or eating more fruits and vegetables). The program has attracted more than $350,000 in funding from the Walmart Foundation through National 4-H Council over the past 10 years. This work is also supported by the U.S. Department of Agriculture’s National Institute of Food and Agriculture, 1890 Extension Formula Program projects under Section 1444.
YOUTHS, FAMILIES & COMMUNITIESReal-world challenges facing food security, agriculture and natural resources prevent better understanding and implementation of associated best practices. Currently, agricultural productivity, effective environmental management practices, wellbeing of ecosystems and overall environmental sustainability face impacts of global warming, climate change, water security and sustainable agriculture. For that reason, Prairie View A&M University researchers used goats, cattle and poultry to conduct original studies in ruminant nutrition, reproductive biology, growth and development, functional genomics and meat science.
Researchers identified sperm fertility markers that advanced andrology and aided in evaluating semen quality and predicting male fertility. Genome to phenome research enhanced livestock production systems. Poultry research led to an eco-friendly and sustainable system for production of broilers with quality meat. This area of study empowered students with knowledge and skills in meat science.
In addition, researchers seek to tackle the concerns surrounding food security in Texas communities by emphasizing storage after harvesting, conversion of food and solutions that involve the community. Disaster management holds
importance in addressing the consequences of disasters on underserved populations. This issue highlights the significance of being prepared, trained and fostering collaboration to ensure communities can be resilient and mitigate from disasters.
Also, Black farmers in Texas were empowered with knowledge of the U.S. Department of Agriculture guaranteed loan programs. The pricing mechanism at the U.S. meat goat auction markets and insights into consumer preferences for goat meat increased research on goat farming and its impact.
According to the South Carolina 2021 report card, only 42% of students read and write at grade level. To provide lifelong learning opportunities to help rural and urban limitedresource youths improve their quality of reading, the South Carolina State University 1890 Research and Extension’s 4-H Youth Development Program incorporated reading into their science, technology, reading, engineering, art/agriculture and mathematics (STREAM) as a program thrust. Discovering potential opportunities that would help boost student literacy became a priority for the 4-H team.
To promote the importance of literacy, South Carolina State 1890 Extension received a grant, valued at approximately $336,782.62 in new children’s books, by the California-based

Molina Foundation. A total of 30,259 storybooks, featuring fun themes and characters, were donated to the program.
To kick off the initiative, Extension educators conducted a statewide literacy tour in which each of the seven service regions distributed books to limitedresource individuals, schools,
libraries and day care centers.
After the reading sessions, youths were gifted with books to take home and encouraged to read to their family members.
To date, approximately 10,000 books have been distributed to help children, parents and caregivers create word-filled homes through reading.
The Agricultural Resource Management Survey (ARMS) of field crop producers, jointly administered by the U.S. Department of Agriculture’s (USDA) National Agricultural Statistics Service (NASS) and Economic Research Service (ERS), indicates that 70% to 80% of larger farms are more likely to adapt existing smart technologies for both high yield and profit.
However, small and local farmers are less likely to adapt existing
smart farming technologies due to operating and equipment costs, resulting in yield losses with a high margin and affecting the quality of crop production. Also, in recent years, plant diseases have expanded with a greater loss of vegetation and yield production.
Hence, South Carolina State University’s research team conducted a training session on artificial intelligence (AI) and drones for local farmers. The producers gained knowledge
on the application of advanced technology in farming through hands-on application. Each farmer received an iPad to take photographs of their farm to help visualize plant health. Objectives included participants collecting soil image and plant image data using a drone and collecting weather data from various zip codes.


The project also supported six undergraduate research students (five computer science undergraduates and one engineering student), who gained research experience in plant diseases, programming skills and AI algorithms. The student research team collected diseased and non-diseased plant leave samples, dry and wet soil samples, and applied AI algorithms on the collected samples to evaluate the models.


The Southern University Agricultural Research and Extension Center (SU Ag Center) is the fifth campus of the Southern University System. Established on July 1, 2001, the center serves 48 of 64 parishes in Louisiana. The Ag Center provides services to Louisiana citizens in a manner that is useful in addressing their scientific, technological, social, economic and cultural needs in order to enhance their overall quality of life.
The College of Agricultural, Human and Environmental Sciences has three departments offering degrees that prepare students for various cuttingedge careers. The Research Unit
focuses on agricultural, natural resources, environmental and climate smart agriculture, animal science specialty crops and research, food science and nutrition, urban forestry and agricultural farm technology.
For 48 years, the Extension program has been the educational outreach arm of the university with areas in community, economic and small business development, agriculture and natural resources, nutrition, health and wellness, and youth development. The program also has a satellite campus called the Sustainable Agriculture Rural Development Institute, which serves a 10-parish region in southwest Louisiana
Grow jAGs seeks to address the recruitment and retention of food and agricultural sciences (FAS) students using the science, technology, engineering, agriculture and mathematics
and a mobile education and technology center that can bring live instructions to any parish within the state. To learn more about the program and other initiatives, visit www.


Students gain hands-on experiences and first-hand knowledge about career opportunities in agriculture, family and consumer sciences, and natural sciences.
(STEAM) principles in practices, problems and processes in FAS.
College and high school students are learning how FAS is steeped in STEAM principles and practices. The objectives of the project are to develop a mobile
lab (Grow jAGs Mobile) that will introduce youths to the College of Agricultural, Human and Environmental Sciences, to establish long-term on-campus and off-campus pipelines for recruiting students to FAS and to conduct a Grow jAGs summer student experiential learning module. The focus is to expose more than 4,500 students over three years and boost the enrollment level in the FAS program by 30% each year.
Students who have participated in the summer experiential program have a 100% conversion
rate to enrolling in the university their freshman year. Students who have participated in the program while in college have also received summer internships and scholarship offers to help them advance in their college careers.
Grow jAGs exists to meet students where they are and give them what they need. Using the Grow jAGs Mobile Unit as a recruiting tool allows potential students to see the possibilities in FAS and how they can be successful in the field.
The Southern University Agricultural Research and Extension Center hosts the JAGcation Summer Camp, a multi-faceted approach and design, focusing on youths in agriculture. The camp has immersed students in a diverse array of concepts and careers within agriculture and family and consumer sciences. Under the guidance of dedicated agricultural specialists,
researchers and academicians, participants explore animal science, entomology, food science, nutrition, plant and soil sciences, and public health. Many middle school students lack exposure to careers in food and agricultural science.
Through a hands-on, experiential approach, this camp is not just a summer pastime but an avenue for knowledge expansion, career exploration and personal
development. The JAGcation Summer Camp is set to embark on a continued odyssey of

Milagro Berhane, Southern University Ag Center senior research assistant, discusses the parts of a flower with a group of JAGcation participants.
discovery, growth and profound impact, firmly positioning itself within the promising landscape of youths and agriculture’s future.
In 2022, 89% of surveyed participants rated their overall
experience as good and excellent, and 83% of participants stated they would recommend the experience to their peers.
The goal of the JAGcation Summer Camp is to ignite
Grapes are the highest-value fruit crop in the United States with an estimated value of more than $6.5 billion. Louisiana has a growing wine industry and there are seven operational vineyards and wineries in the state that produce a variety of wines. These vineyards primarily grow Pierce’s diseases (PD) tolerant American, French American hybrid bunch grapes and Muscadine grapes. Southern University’s Agricultural Research and Extension Center has sustained a modest viticulture research program for the last decade. Through support by the Evans Allen and U.S. Department of Agriculture’s National Institute of Food and Agriculture 1890 Capacity Building grant, the center has increased its research efforts since 2019.
awareness and knowledge within youths about potential careers in the food, agricultural, natural resources and human sciences.

Scientists at the center assessed the performance of different PD tolerant bunch and muscadine grapes (Crimson Cabernet and Cabernet Franc; popular bunch grapes Blanc Du Bois, Stover and Lenoir; table grapes Villard Blanc and Victoria red; Noble and Carlos).
Preliminary results suggest that existing and newly released hybrid bunch and muscadines can be adapted to the different soil types in Louisiana. Development and evaluation of these new PD tolerant bunch and muscadine grapes can provide greater economic opportunities for farmers and the wine industries.
The project and establishment of viticulture research have helped complete four undergraduate
honors theses and sparked interest in students for horticulture research and small fruit production. Research faculty are also partnering with two wine companies, the McBride Sisters and the Darjean Jones Wines Company, which offer scholarships and internship opportunities for undergraduate students in plant science. The McBride Sisters Collection also provided $50,000 through the “YES SHE CAN” fund for student and faculty development in viticulture and enology.
The College of Agriculture houses two academic departments, plus the Institute for Agricultural and Environmental Research, and the Tennessee State University (TSU) Cooperative Extension Program. Through these entities, the college fulfills the tripartite mission of the land-grant system’s teaching, research and Extension.
Research is performed in 34 state-of-the-art research laboratories on the main campus and three outlying Agricultural Research and Education Centers.
TSU’s research caliber is wellrecognized at the national level as faculty continue to excel in winning competitive research grants from agencies such as the National Institute of Food and Agriculture and the National Science Foundation.
Extension programs are conducted in 60 of the 95 Tennessee counties with
Extension agents jointly funded by county, state and federal appropriations. Seven of these counties also have the TSU Supplemental Nutrition Assistance Program. TSU Extension has the largest county operation among 1890 institutions. Programs are conducted jointly with the University of Tennessee Extension programs.
The Department of Agricultural and Environmental Sciences offers a Bachelor of Science in Agricultural Sciences and three Master of Science degrees
departments of Food and Animal Science, Environmental Sciences, and Agriculture Business and Education will be added to the college.
The Department of Human Sciences offers a Bachelor of Science in Family and Consumer Sciences with concentrations in child development and family studies; fashion merchandising and product development, consumer sciences leadership, education and communication; food service management; and food and nutritional

The Tennessee State University (TSU) and Vanderbilt University (VU) partnership, Earth Horizons, is poised to make a significant impact on the geosciences and environmental fields with far-reaching implications for underrepresented minority students, academic institutions and the broader community.
The TSU-VU partnership is a catalyst for transformative change. It not only provides students with the skills and opportunities needed for successful geoscience careers but also sets a precedent for collaboration, diversity and inclusivity within the geosciences field. By breaking down barriers and fostering partnerships, this initiative has the
potential to reshape the future of geoscience education and professions in Tennessee and across the nation.
As a result, the TSU-VU partnership has made a significant impact since its inception with more than 250 students participating in the program. These students have been engaged in various activities to prepare them for successful earth and environmental careers in multiple sectors.


Through the program, students have gained practical experience through research opportunities and internships with external stakeholders and universities, providing them with valuable real-world insights and a
competitive advantage in the geoscience workforce. This not only fosters academic and professional growth but also helps students develop a deep passion for their chosen field. Students who have landed prestigious internships at Woods Hole are a testament to the program’s success in opening doors to exceptional opportunities for its participants.
ENVIRONMENTAL STEWARDSHIPConsumer drones, unmanned aircraft systems (UAS), have huge potential for use in sustainable agricultural systems. According to the American Farm Bureau Federation, the use of UAS in agriculture could provide a return on investment of $12 per acre for corn and $2 to $3 per acre for soybean and wheat. These UAS have been used in the determination of soil properties, weed prevalence, yield, plant cover and plant nitrogen concentrations, precision chemical application, plant pathogen detection, drip irrigation performance and plant water status.
However, the U.S. commercial UAS market lags behind other countries in South America, Asia and Europe. In Tennessee, 78% of Tennessee agricultural Extension agents believed that producers in their respective
counties would be interested in workshops related to using drones in agriculture and 85% believed that drones could help producers sustainably manage their farms.
For that reason, a series of workshops were implemented across 13 counties in Tennessee between 2019 and 2022 and provided more than 250 farmers with hands-on drone training. These workshops also included examples of uses for drones in agriculture, drone laws and regulations, drone options, sensors, software and costs.
Following the workshops, evaluations indicated a significant increase
in participants’ knowledge, awareness and interest in drones. About 95% indicated an increase in their knowledge, 70% realized that drones were not as difficult to fly as they originally thought and 54% increased their likelihood of purchasing a drone in the next two years.


Soybean is one of the world’s most important crops. It is grown for its edible beans, which have many human, animal and industrial uses.
Breeding soybeans for improved traits can be difficult because much of the genetic diversity normally used in breeding was lost during the domestication of the crop in Asia and through the breeding methods used since then. One way to create genetic diversity is by inducing mutations on purpose called mutation breeding. In this process, seeds are exposed to radiation or chemicals that is capable of damaging the DNA. Therefore, scientists at Tennessee State University are using mutation breeding techniques to improve the oil and nutrition content of soybeans. Using a soybean line that was developed to grow well in the Southeast U.S., they recovered plants that
had up to two times (40% to 50% concentration) the content of oleic acid as parental soybean. Breeders will now use standard breeding techniques to intercross these plants with a target to obtain an oleic acid content similar to olive oil (about 80%). The program is also looking at other components of the soybean seed. In addition to an oil source, soybeans are used as a protein source in animal foods. Standard soybeans have a high level of raffinose. Many animals cannot digest raffinose well, resulting in gastric problems. Several lines with decreased raffinose content have been identified in the mutant population. These plants will be intercrossed to create improved low-raffinose varieties to be used for animal feed. The result of this research will provide farmers in the Southeast with high-value improved crops to enhance their profitability.
There is a growing need in the agricultural workforce to feed, clothe and house more than 9 million people by the year 2050. Consequently, there is a demand in the agricultural workforce for qualified candidates and college graduates to fill the number of job vacancies in the federal government. Unfortunately, these growing career opportunities are not met with prepared students from minority groups, particularly those with backgrounds in science, technology, engineering, agriculture and mathematics (STEAM). The issue is that there has not been a sustainable experiential learning and mentoring in agricultural education for the development of a professional and diverse workforce.
Therefore, in the past 10 years, Tuskegee University’s Future Farmers and Agricultural Specialist (2FAS) program has engaged more than 200 high school and college students in
three apprenticeship and training programs: Summer Agents, Carver Integrative Sustainability Center Summer Experience and the Tuskegee University Cooperative Extension Intern Program. Students worked alongside local farmers, Extension agents, agribusiness entrepreneurs, rural policy experts and natural resource professionals. They also worked with the local farmers market while learning small-scale farming techniques, Good Agricultural Practices (GAP), Good Handling Practices (GHP), soil and water conservation and marketing.

As a result, high school students, undergraduates and graduate level interns reported
an increased awareness of agriculture careers and food-related businesses. All participating students gained knowledge of the operating components of a food system and how these components can be influenced. In addition, 95% increased their knowledge in the use and application of geographic information systems, and 82% indicated an increased likelihood to pursue a career path in agriculture and related sciences.
YOUTHS, FAMILIES & COMMUNITIESAn alarming number of young children and teens are disconnected from the mainstream of society. They have been labeled “at risk” because of the harsh realities of their lives. If these young people remain disconnected, we will lack the skilled, motivated workers to sustain our economy. We will have denied these young people the chance to lead healthy, fulfilling, productive lives. Therefore, Tuskegee University Extension educators offer the
Extension, Education and Research Track (EXERT) to educate students on character development, as well as science, technology, engineering and mathematics (STEM), nutrition and obesity, community development and personal finances. The virtual EXERT summer camp further establishes these hallmarks of character, citizenship, teambuilding activities, agricultural and planting activities, hiking and tree identification, art,

reading, writing and reflection, swimming, fishing and other recreations.
Results indicated that of the 800plus students who participated in the EXERT program in the past two years, 88% reported they increased their knowledge of sciences, including basic science, tools of science and the scientific method. In addition, 90% reported an increase in their ability to apply science, including agriculture, engineering, design and culinary arts. Also, there were improved youth outcomes in physical and mental health and awareness of food, agricultural and environmental systems for the future.
The School of Agriculture, Fisheries and Human Sciences at the University of Arkansas at Pine Bluff (UAPB) strives to make an impact at the local, national and international levels. The school aims to recruit students from underrepresented minority groups to pursue education and careers in food, agriculture, aquaculture and fisheries, natural resources and human sciences. The Office of International Programs and Studies ensures these students are better equipped for globally-oriented careers and collaboration through its premier study abroad programs. In addition, UAPB is committed to pushing the envelope in cutting-edge research
opportunities related to the environment, energy and climate, access to safe and nutritious foods, agriculture production and processing, and agriculture and natural resources economics and marketing.
UAPB’s 1890 Cooperative Extension Program personnel also help community members make a positive change in their lives through proper nutrition. Specialists help underserved livestock farmers and ranchers improve their grazing and management practices, parasite control, and environmental and economic sustainability.
Comprehensive Extension programs and services include diagnostics to identify fish diseases and water quality problems, as well as 4-H
A shortage of graduates and the lack of diverse candidates in the field of food, agriculture, natural resources and human sciences (FANH) pose a threat to agricultural and other industries in the United States.
To address these issues, the
programming for youths in Jefferson County, Arkansas and surrounding communities. Also, the Small Farm Program assists socially disadvantaged producers, limited resource producers and small producers.
A project devoted to sustainable forestry provides educational resources and technical assistance to African American forest landowners to protect and retain their family land for future generations.
Furthermore, local families can take advantage of the UAPB Early Head Start-Child Care Partnership, a research-based initiative designed to provide family-centered services for lowincome families. These are just some of the ways UAPB lives up to its land-grant mission.
University of Arkansas at Pine Bluff (UAPB) is involved in several land-grant university (LGU) partnerships with
North Carolina Agricultural and Technical State University, Fort Valley State University, Florida A&M University, Tuskegee University, University of Maryland Eastern Shore and Virginia State University to strengthen the selection of graduates in these academic areas.
UAPB is a co-recipient of the U.S. Department of Agriculture’s
National Institute of Food and Agriculture From Learning to Leading: Cultivating the Next Generation of Diverse Food and Agriculture Professionals (NextGen) grant. The goal is to build and sustain a next generation workforce by providing student scholarships, paid internships, fellowships and job opportunities in the federal public sector.

The University of Arkansas at Pine Bluff is building a next generation workforce by providing student scholarships, paid internships, fellowships and job opportunities.
An increasing number of grandparents are raising their grandchildren, making it essential to provide them with the necessary resources and support. One way the University of Arkansas at Pine Bluff (UAPB) has supported them is by helping
Also, an initiative led by North Carolina A&T is expected to increase the number of students persisting and succeeding at each major juncture along
them to grow their own food.
A partnership between UAPB’s School of Agriculture, Fisheries and Human Sciences, the Arkansas Cooperative Extension Office in Jefferson County and the Pine Bluff First Assembly church brought together
the education-to-workforce pathway. In this project, which includes the participating land-grants, students will receive assistance to ease their navigation to graduation and a career. Opportunities include scholarships, mentoring, experiential learning, undergraduate research and studying abroad.
Currently, LGUs produce approximately 36,100 graduates in FANH each year. It is estimated that 60% of the workforce is still needed to fill nearly 60,000 jobs. This project is expected to narrow the gap between the supply of graduates and the number of jobs in those careers.
grandparents and their grandchildren for an experience of planting and harvesting produce at a community garden.
Guided by university project leaders, grandparents and their grandchildren planted and

their
cared for an assortment of fruits, vegetables and herbs. Through the Extension initiative, participants were also educated about stormwater, effective parenting, sweet potato production management and communications.
Ten grandparents and seven grandchildren are involved in the project. One grandparent said, “I’m very thankful for the gardening program and the experience it has given
my family. A portion of our church backyard has been transformed from a lawn to a vibrant community garden. I believe this is the third year, and each year has brought a better experience, new faces, additional veggies and fruits and a plentiful harvest until late fall. Thank you, UAPB, for keeping us connected and teaching us to thrive off the land.”
Another participant said, “The garden gave me the opportunity to utilize some of my gardening skills I learned in my childhood. As a bonus, I watched our community enjoy a variety of organic food from the garden.”
Agricultural waste can be a nuisance for producers and lead to environmental degradation. Refuse, including livestock manure and crop residues and byproducts, can introduce pesticides, antibiotics and other chemicals into soil and water systems. These pollutants are
harmful to the environment and threaten human health if found in drinking water. Solutions are urgently needed to address the problem of agricultural waste management.
Researchers at the University of Arkansas at Pine Bluff (UAPB) are studying the potential of converting plant and animal
byproducts to multifunctional biochar (charcoal made from biomass). Biochar products are used as a sustainable soil additive to improve crop yields and can reduce the ecological risks associated with common agricultural chemicals. Though it looks like regular charcoal, biochar captures agricultural chemicals from the local
environment. The product is added to soil through tilling and absorbs and degrades pesticides, antibiotics and other undesired chemicals during agricultural production.
UAPB research has shed light on using biochar to tackle soil contamination and suboptimal plant growth. Key impacts include understanding biochar’s high-pore structure, which helps bind contaminants and diminish their ecotoxic effects on plants and microorganisms. Furthermore, in problematic soils where traditional agricultural practices often fail, biochar has demonstrated
the potential to promote plant growth. Beyond its direct agricultural benefits, biochar also acts as a carbon sink, sequestering carbon and mitigating the impacts of climate change.
The application of biochar presents a cost-effective solution for farmers dealing with contaminated farmland. By making their land more productive using these soil additives, they can increase their crop yields and profits. Consumers also benefit from safer, contaminant-free produce. ENVIRONMENTAL
 STEWARDSHIP AGRICULTURAL SYSTEMS
STEWARDSHIP AGRICULTURAL SYSTEMS
of Maryland and the nation. The university’s mission also addresses current and future societal challenges in the food, agriculture, natural resources and human science sectors. This innovative work is anchored in the School of Agricultural and Natural Sciences.
The work of the UMES
Agricultural Experiment Station and Extension is organized around five strategic areas:
• Agriculture and resource sciences with an emphasis on food production and safety, and nutritional security: This area encompasses work on
• Natural resources and environmental sustainability: Maryland’s natural resources underpin a range of economic activities, such as forestrybased industries, tourism and fisheries. Taking this into account, this focus area provides the basis for maintaining quality living and supporting the livelihoods of Marylanders. This work ensures a strong, sustainable foundation to guide use and protection of these resources.
• Human health and development: Recognizing the health, social and economic
well-being, and resilience of communities are important issues for Maryland. This work focuses on youth development, along with supportive activities for healthy and resilient
families and communities.
• Development of products to market.
• International engagement and development.
The Delmarva Chicken Association generated $5 billion in wholesale value in 2022, supporting approximately 1,300 farm families raising chickens and 18,300 poultry company employees. Another economic driver in the region is the Chesapeake Bay watershed, which encompasses no less than six states and the District of Columbia with a footprint of $18 billion. What these two industries have in common is attracting new and competent employees.
The University of Maryland Eastern Shore (UMES) strives to educate and train the next generation of teachers, educators, researchers and scientists. UMES plays a critical role by providing access and opportunities for many who would otherwise not be able to receive a college education.
The School of Agricultural and Natural Sciences offers eight undergraduate degrees, five master’s and three doctoral programs in food, agriculture, natural resources, human sciences and related disciplines. The UMES Agricultural Experiment Station and Extension provide relevant opportunities for experiential training. Additionally, concerted efforts support students in obtaining experiential training in the public and private industry. Furthermore, students are engaged in global training and activities through the 1890 Universities Centers of Excellence for Global Food Security. This ensures UMES produces workready graduates. One of the
UMES strives for excellence and impact in an inclusive environment that prioritizes the needs of diverse individuals and families.
signature academic programs is the graduate program in food and agricultural sciences. Graduates can be found working for the local poultry industry and other agro-related industries. Others hold faculty and research positions at national and international universities or at state and federal public agencies.
The school aims to provide education, research and services that positively impact students, as well as the Delmarva Peninsula, state, nation and world.


Smallholders, minorities and underserved farmers need financial, technical and managerial support to improve their decision-making capabilities, mitigate risk and engage in data-driven farm planning and budgeting to build capacity for sustainable farming. The Farmers’ Needs Assessment in Agriculture (FNAA) conducted in 2022 revealed that adults and youths were unaware of the importance of urban agriculture, producing fresh food locally and adopting climate-smart agriculture and forestry practices. The 124
FNAA respondents cited a lack of capital, access to cross-cutting technological information, education on capacity building and efficiency, access to valueadded marketing of agricultural commodities produce processing facilities, knowledge and skills on production technology, and farm business planning and management skills among their concerns. In addition, most participants were prone to unhealthy eating habits, minimal or no fresh food in their daily diets, inactive behaviors, higher health costs and grocery bills, and increased greenhouse gas emissions in food transportation.
To address these concerns, UMES Extension focused on small farm programs, urban and alternative agriculture and the production of specialty vegetables and herbs. Specific deliverables included interactive hands-on training, field days, peer-to-peer and market networking, the formation of the Around the Bay Farmers’ Alliance and the Vibrant Farmers’ Group of Urban Agriculture, and other opportunities.
As a result, 1,187 producers and 147 professionals gained knowledge and skills on small farm improvement, and 378,500 pounds of fresh food was produced. Although most of the food was consumed, 25.14% sold and 10% shared with sales estimated at $142,800. The participants also adopted healthy eating habits, saved on food costs, contributed to household food security and promoted the overall well-being of the community.
Food safety is a global concern for 600 million people who fall ill after eating contaminated food and the estimated 420,000 who die each year. In the United States, the Food Safety Modernization Act of 2011 addresses more than 48 million illnesses per year caused by food that could largely have been prevented with better manufacturing, packaging, distribution and holding practices.
The Delmarva Peninsula (comprised of the Eastern Shore

of Maryland and Virginia, and part of Delaware) is noted for poultry, fresh produce and seafood. Since 2002, the University of Maryland Eastern Shore (UMES) has conducted research on these foods. This research involves understanding the ecology, persistence, transmission, antimicrobial resistance, pathogenicity, genetic diversity and control of food and waterborne pathogens in different foods and their surrounding environments. The results have led to safer food products. A research team developed predictive models to understand the behavior of vibrio bacteria in oysters and Listeria
monocytogenes in blue crabs, as well as evaluated the effects of aquaculture practices on vibrio and microbiome of oysters and water. In addition, researchers developed an environmentally friendly approach to control ammonia emission in poultry houses and economically convert the ammonia to liquid nitrogen fertilizer.
UMES’ research program is cutting-edge, timely and relevant nationally and internationally. It not only makes significant research contributions to food safety and water quality but fosters formal and non-formal training of diverse groups of people. The goal is to develop the next generation of scientists and increase diversity in food safety. The team has mentored undergraduates, along with graduating nearly 40 master’s and doctoral students.
FOOD SECURITY
Virginia State University’s (VSU) College of Agriculture excels in its commitment to agricultural innovation, integration and sustainability. The institution actively engages in research to promote sustainable farming techniques and environmental conservation, addressing the growing demand for responsible agriculture in a changing global
Student success, experiential learning and workforce development are at the core of the college’s mission. They provide students with hands-on experiences, internships and research opportunities to prepare them for successful careers. The college’s scholarship programs, such as the U.S. Department
of Agriculture 1890 Scholars Program and the VSU Food and Agri-Science Scholarship Program, ensure that financial constraints do not hinder students from accessing a quality education. Through programs in family and consumer sciences, the college delves into health, nutrition and family dynamics, emphasizing the holistic development and well-being of Virginia’s families.
In addition to academic programs, the College of Agriculture distinguishes itself through its extensive research initiatives, which contribute to the broader agricultural ecosystem of the state. They actively engage in applied research to drive realworld solutions.
The college’s programs like the Small Farm Outreach Program and Virginia Cooperative Extension underscore its dedication to positively impacting the lives of Virginia’s citizens. It extends support to historically
underserved communities, ensuring they have access to vital resources for their well-being.
Also, the 4-H and youth
programs play a pivotal role in engaging the younger generation in agriculture, instilling values of community, leadership and learning. This commitment to
In the forefront of experiential learning, the Virginia State University College of Agriculture’s Hospitality Department stands out for its impact on workforce opportunities. Beyond traditional internships and networking with industry leaders like Disney, MGM, Explore Charleston Intern Cultural Enrichment Program and Hyatt Hotels, the department strategically aligned with Retro Hospitality. This alliance, enriched by a $1 million donation from Thompson Hospitality, significantly enhances students’ real-world experiences.
Through the Retro Hospitality partnership, students actively contribute to the restoration and management of Hotel Petersburg in downtown Petersburg,
community engagement sets the college as a catalyst for change in the agricultural sector, shaping the next generation of leaders and ensuring a brighter future for all.

Virginia. This hands-on involvement spans various aspects of the food and beverage industry, upscale dining and hotel management, providing invaluable skills for Virginia’s dynamic hospitality sector.
The response to the Retro Hospitality alliance has seen increased student interest, bridging the gap between classroom learning and real-world application. Events like “What’s Up Wednesday,” a Lecture Series curated by Dr. Berkita Bradford, offer networking opportunities and industry insights, increasing student immersion.
The impact is reflected in the hospitality department’s exceptional 2022 job placement
rate of more than 75%, showcasing the success of the comprehensive approach. Students, well-prepared through practical involvement and networking events, contribute to Virginia’s thriving hospitality sector, supporting local workforce development and economic growth. The $1 million donation from Thompson Hospitality further cements the department’s commitment to shaping industry leaders, offering an enriched educational experience that contributes to workforce development and economic vitality in Virginia.
YOUTHS, FAMILIES & COMMUNITIES Thompson Hospitality giftsThe National Urban Agriculture Initiative, spearheaded by Virginia Cooperative Extension’s Small Farm Outreach Program (VSU-SFOP) within the VSU College of Agriculture, serves as a powerful response to the pressing challenge of food insecurity. By bridging the gap between urban farmers and the U.S. Department of Agriculture’s Farm Service Agency (FSA), this initiative directly addresses the needs of communities grappling with limited food access.
This impactful initiative has facilitated a transformative response from urban farmers. Through collaboration with Cornell University’s Small Farm Center (CU-SFC), Virginia Tech University (VT) and the FSA, the program has empowered urban farmers with essential knowledge, resulting in improved access to FSA programs. Urban farmers now have FSA farm numbers, enabling them to benefit from loans, crop insurance and
Electronic Benefit Transfer card acceptance, thereby enhancing their agricultural productivity and income.
The initiative’s far-reaching results are evident in the allocation of approximately $3.25 million for the National Urban Agricultural Program, launched in July 2023. This substantial investment lays the groundwork for a four-year venture that will equip urban growers across the nation with the knowledge and expertise needed to maximize FSA services and ensure their success.
The collaboration between VSU-SFOP, VT and CU-SFC has
also established evidence-based best practices. These practices are becoming a model for other states to adopt, amplifying the impact of the initiative beyond Virginia. The National Urban Ag Kick-Off in Atlanta, Georgia, brought together leaders and workers in urban agriculture, emphasizing skill enhancement, increased access to fresh produce and improving the well-being in 17 pilot cities nationwide.


The completion of the MT Carter Annex at Virginia State University (VSU) represents a significant milestone for the College of Agriculture, signaling its commitment to cuttingedge research and education. This state-of-the-art facility underscores VSU’s dedication to equipping students with the skills needed in the evolving agriculture industry.
The impact extends beyond academia to the agriculture industry and the broader community. The annex addresses the need for advanced research infrastructure, ensuring students are well-prepared to meet industry demands. The sustainable design aligns with environmental stewardship, reflecting VSU’s commitment to sustainable practices.
Response to the MT Carter Annex has been overwhelmingly positive. It has become a center for innovation, facilitating collaborative research and modern teaching methods. The
The MT Carter Annex expands research capabilities essential for driving innovation and collaboration in critical fields such as food science, environmental and plant science, animal science, biotechnology and nanotechnology. With a flexible floor plan designed for modern teaching methods, the facility empowers students, faculty and researchers to push the boundaries of knowledge.
sustainable design has garnered praise for its environmental consciousness with electric charging points, reinforcing VSU’s commitment to the future of agriculture.
Results of the annex’s completion are already evident. Upgraded labs support critical research, and flexible spaces enhance the dynamic learning environment. The inclusion of electric charging points positions VSU as a forward-thinking institution. The MT Carter Annex stands as a testament to the positive impact of infrastructure investment on research, education and the preparation of students for the agriculture industry, ensuring ongoing advancements in cuttingedge research and sustainable practices.

West Virginia State University (WVSU) Extension Service provides free educational resources to the citizens of West Virginia. Its focus areas include research, agriculture and natural resources, youth development, community and economic development, and family and consumer sciences. The program is committed to improving the lives of West Virginians by providing access to knowledge and expertise and strongly
focuses on community-based research that addresses realworld problems.
WVSU Extension offers a wide range of programs that are designed to give residents the tools they need to succeed. The public can take online courses and workshops in a variety of subjects. This allows people to learn at their own pace and on their schedule. Offered courses cover topics like business, agriculture, and health and
wellness. They are taught by experienced professionals in each field.
In addition, WVSU’s research projects cover various topics from food systems to sustainability. These educational programs offer students the chance to conduct original science, social sciences and humanities research. The studies are often groundbreaking and can positively impact the community.
Jobs that require science, technology, engineering and math (STEM) skills continue to grow at higher rates than other occupations. To meet this growing demand, educational institutions like West Virginia State University (WVSU) focus on preparing students for success in STEM careers.
WVSU partnered with Toyota Motor Manufacturing to offer a STEM Career Series program called Yellow Jacket Innovators. This program introduces middle and elementary school youths to STEM activity kits designed to enhance creativity, critical thinking and problemsolving skills. During the pilot phase, two themed boxes were developed, allowing students to investigate electricity and energy. The second theme focused on engineering and manufacturing and consisted of building a rubber band-powered car, 3-D printing by hand and assembly lines.
Eighteen WVSU pre-service teachers helped develop and test
the program’s curriculum. As a result, 83% reported learning how to do things they did not know before, 77% increased interest in STEM, 66% want to teach
more about STEM degrees and careers, and 78% increased their confidence in teaching STEM. In addition, five career videos and four career sheets were developed in partnership with Toyota and placed in the activity boxes. The career sheets included information about mechanical engineer, quality engineer, production engineer and production team lead occupations. Three teachers delivered the content boxes at Dunbar Middle School, South Charleston Middle School and West Side Middle School.

middle school students have participated in the program. Of the participating teachers, 100% reported that the boxes helped build their knowledge, reach students and engage students’ interest in STEM careers.
To date, more than 170
YOUTHS, FAMILIES & COMMUNITIES
The West Virginia Tree Minders program addresses knowledge gaps of proper tree care among West Virginia citizens and communities. It extends the reach of limited technical assistance providers in the state through partnerships between West Virginia State University
(WVSU), West Virginia University (WVU), WV Division of Forestry, Glenville State University and professional guest speakers across the nation. The program forged a strong partnership between WVSU and WVU and secured a U.S. Department of Agriculture’s National Institute of Food and Agriculture Capacity Building Grant for $239,146. In addition, it provided participants with online and in-person tree care training courses. It also created new community forest inventories in Wheeling, Charleston, Hurricane and Saint Albans and on the campuses of Glenville State and Marshall Universities.
West Virginia Tree Minders inspired policy changes within
the Wheeling Tree Ordinance and cemented WVSU Extension as a known urban and community forestry resource. It expanded partnerships with Pennsylvania State University and the University of Wisconsin Stevens Point, which helped introduce college students to the field of urban forestry. As a result, 35 students enrolled in the virtual Basics of Urban and Community Tree Care course and two interns from Glenville State and Marshall Universities have pursued careers in the urban forestry field. Since 2021, the program has offered 70 programs involving more than 3,000 participants in outreach activities.
Cancer is a significant health issue worldwide and the second leading cause of death in the United States. In 2023, health authorities estimated that almost 82,000 new kidney cancer cases
were diagnosed, leading to nearly 15,000 deaths.
Healthy lifestyle changes, such as healthy eating, staying active and maintaining a healthy weight, can help to reduce the
risk of getting kidney cancer by 30% to 40%. Additionally, it is estimated that cancer deaths can be reduced by as much as 20% by consuming more fruits and vegetables. Fruits and vegetables
are safer to ingest and are packed with nutrients that prevent sickness. Due to this correlation, doctors and researchers are focusing on the benefits of fruits, vegetables, herbs and natural compounds in the fight against cancer.
For example, West Virginia State University researchers studied watermelon and its effects on kidney cancer cells. Studies have shown that watermelon rinds contain natural compounds, such as an amino acid called citrulline, that have health benefits. When tested on cancer cells, the rind reduced their growth. This reduction occurs because the rind makes the cancer cells self-destruct, a process scientists call apoptosis. Detailed tests suggested that
watermelon rinds might trigger this process in multiple ways. This potential breakthrough not only benefits the residents of West Virginia but people around the world.
 AGRICULTURAL SYSTEMS
AGRICULTURAL SYSTEMS